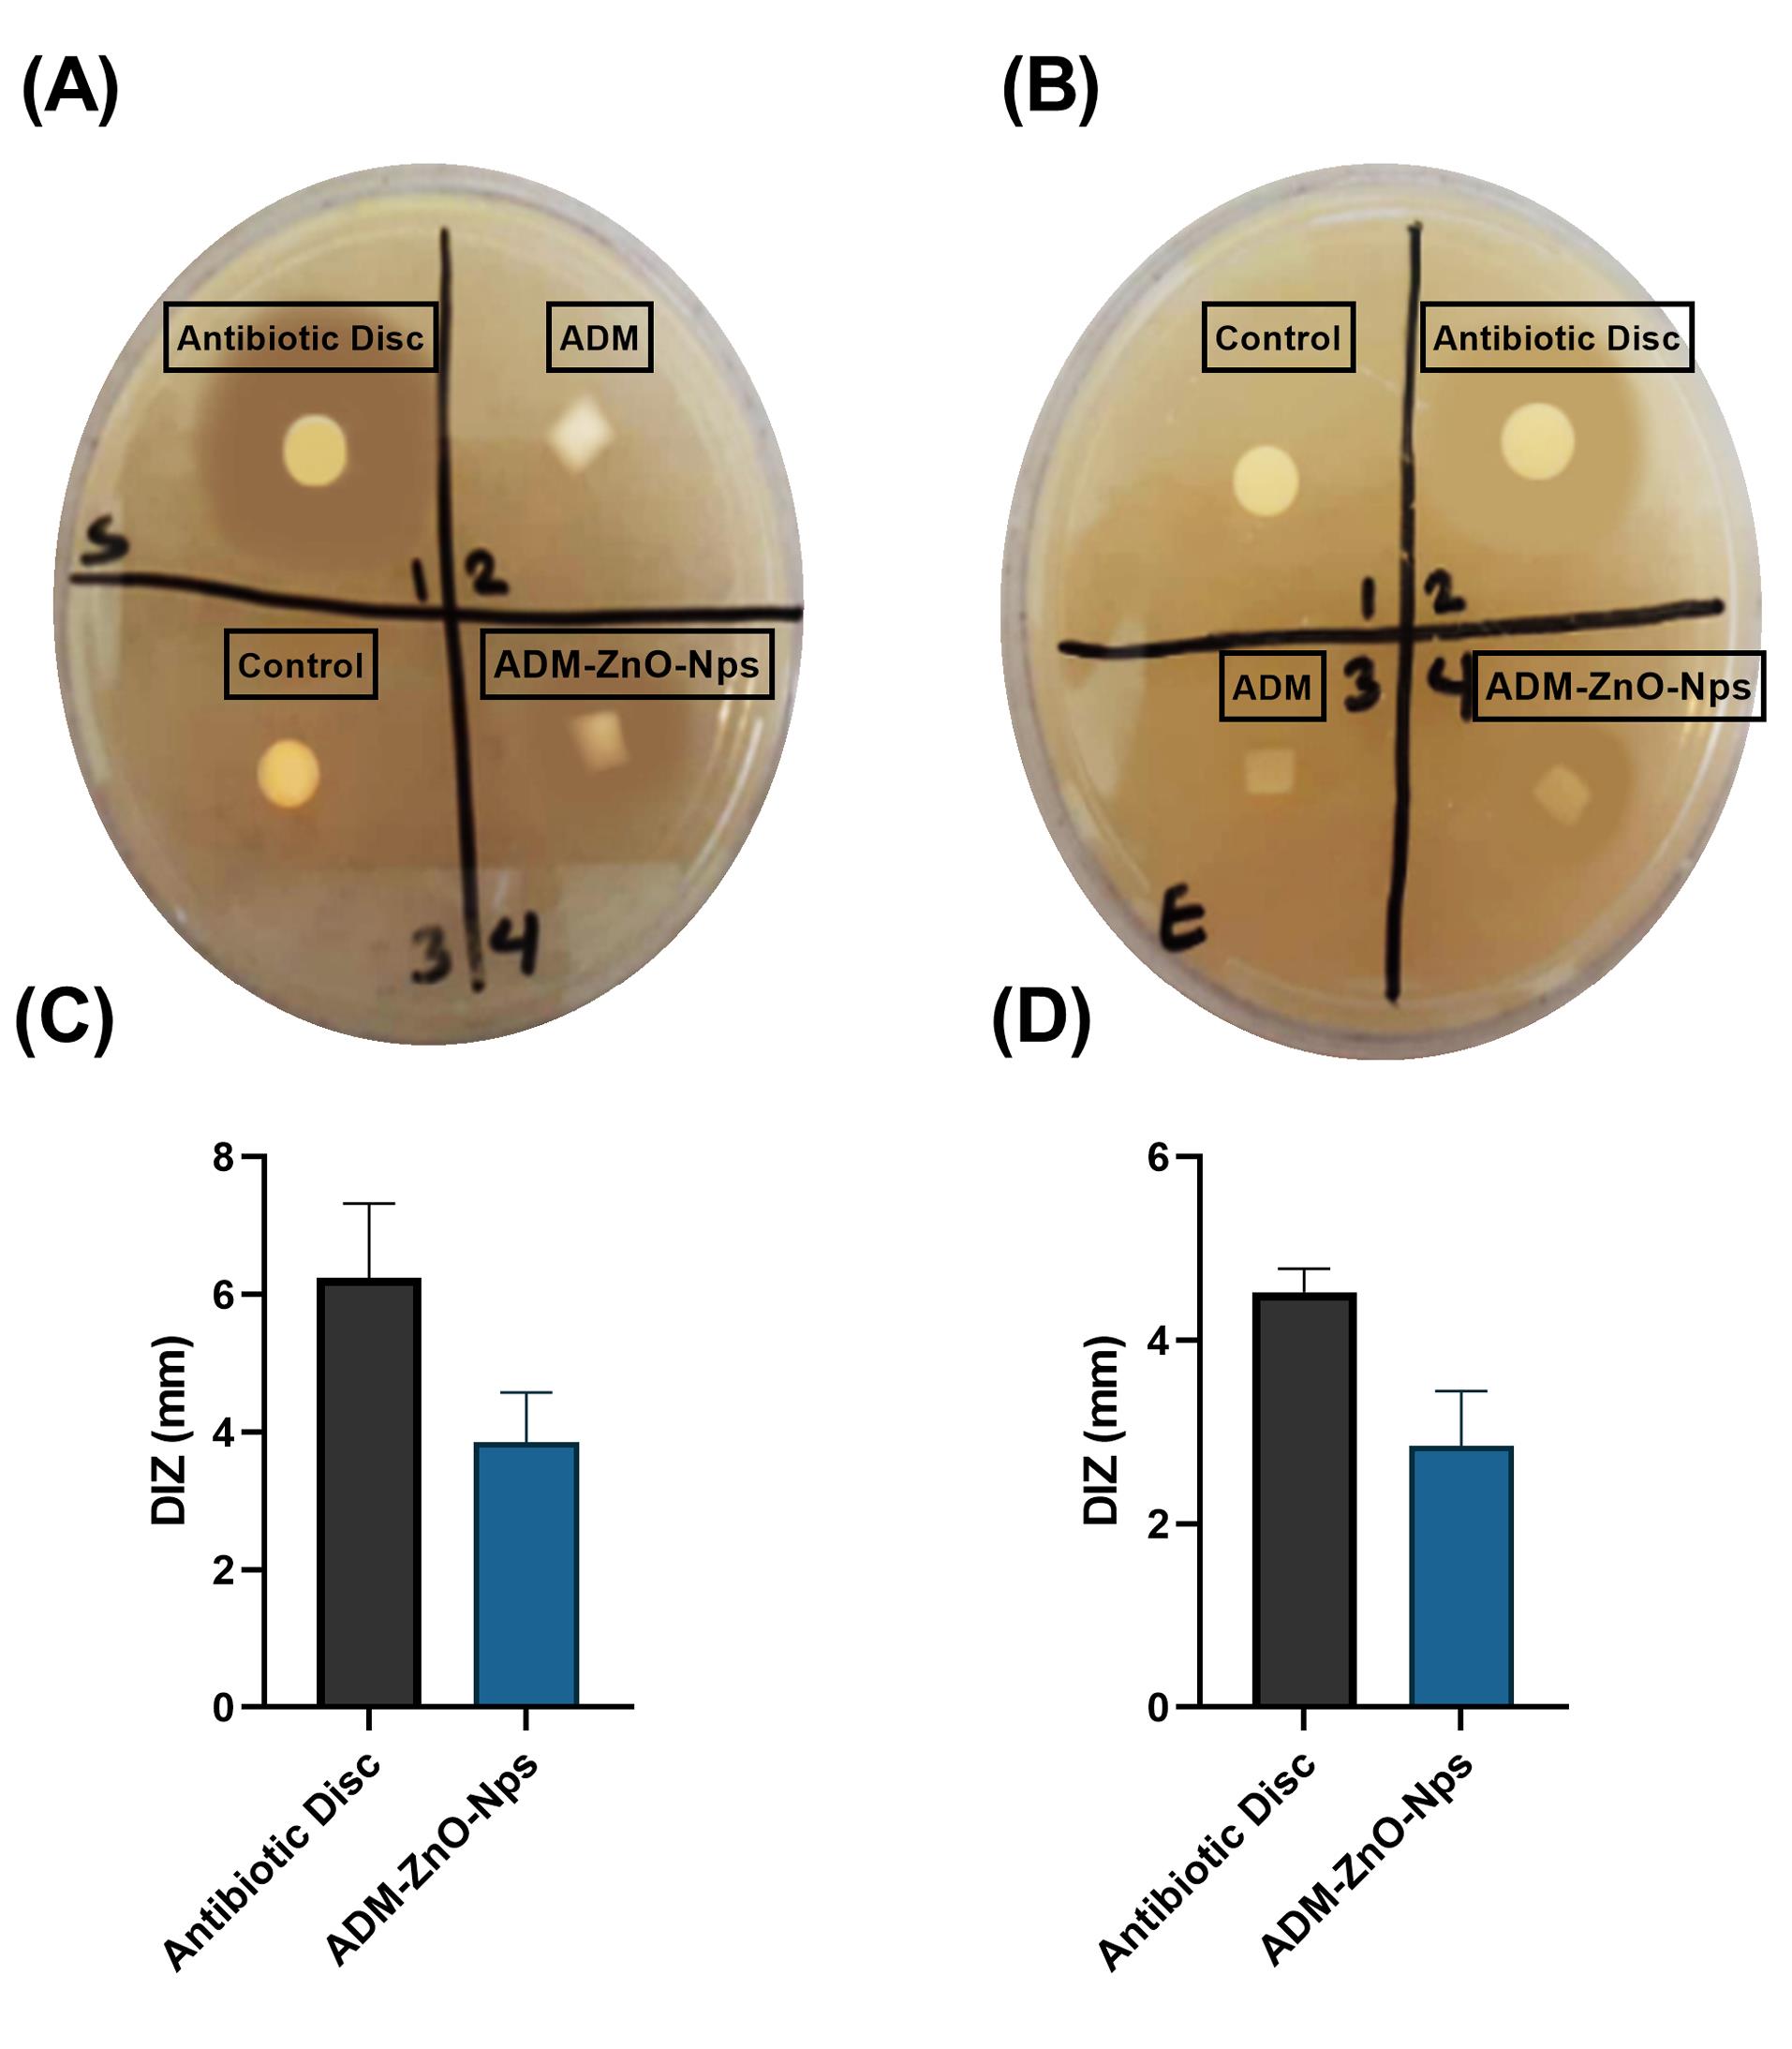
bi-14-27748-g005

Bioimpacts. 14(5):27748.
doi: 10.34172/bi.2024.27748
Original Article
A human acellular dermal matrix coated with zinc oxide nanoparticles accelerates tendon repair in patients with hand flexor tendon injuries in zone 5 of the hand
Seyedeh-Sara Hashemi Conceptualization, Data curation, Formal analysis, Funding acquisition, Investigation, Methodology, Project administration, Software, Validation, Visualization, Writing – review & editing, 1, 2, * 
Mohsen Pirmoradi Data curation, Funding acquisition, Investigation, Software, Validation, Visualization, Writing – original draft, 3
Alireza Rafati Formal analysis, Investigation, Writing – original draft, Writing – review & editing, 4
Mehdi Kian Formal analysis, Software, Writing – original draft, Writing – review & editing, 2, 5
Ali Akbar Mohammadi Conceptualization, Funding acquisition, Methodology, Project administration, Supervision, Validation, Visualization, 1, 3, * 
Mohamad Ali Hoghoughi Conceptualization, Methodology, Project administration, Supervision, Validation, 3, *
Author information:
1Burn and Wound Healing Research Center, Shiraz University of Medical Sciences, Shiraz, Iran
2Department of Comparative Biomedical Sciences, School of Advanced Medical Sciences and Technologies, Shiraz University of Medical Sciences, Shiraz, Fars, Iran
3Division of Plastic and Reconstructive Surgery, Department of Surgery, Shiraz University of Medical Sciences, Shiraz, Iran
4Division of Pharmacology and Pharmaceutical Chemistry, Sarvestan Branch, Islamic Azad University, Sarvestan, Iran
5Student Research Committee, Shiraz University of Medical Sciences, Shiraz, Fars, Iran
Abstract
Introduction:
Flexor tendon injuries are common and require surgery. Acellular dermal matrix (ADM) is a natural graft used to repair tissues, though infections represent the primary cause of its therapeutic failure. In this study, zinc oxide nanoparticles (ZnO-NPs) were coated on the ADM in order to add antibacterial potential as well as enhance healing properties. Also, the produced ADM/ZnO-NPs graft was applied to accelerate fifth zone flexor tendon repair following the reconstructive surgery.
Methods:
Morphological, mechanical, cell viability, and antibacterial tests were performed to evaluate the physical and biological properties of the fabricated ADM/ZnO-NPs graft. For clinical evaluations, 20 patients with a flexor tendon injury in zone 5 were randomly divided into control and treatment with ADM/ZnO-NPs groups (n=10 each). The control group had routine reconstructive surgery, while the other group received the ADM/ZnO- NPs graft during their surgery. Postoperative functional outcomes were evaluated 4, 6, and 8 weeks following the tendon repair surgery according to the Buck-Gramcko II criteria.
Results:
The ADM/ZnO-NPs had natural derm specifications as well as dense and integrated morphology with intermediate antibacterial properties. According to the Buck- Gramcko II criteria, the postoperative functional outcome scores were significantly higher in the ADM/ZnO-NPs group in comparison with the control group at 4 (P<0.01), 6 (P<0.01), and 8 (P<0.001) weeks after the surgery.
Conclusion:
The present findings revealed that the ADM/ZnO-NPs graft can accelerate the healing of the damaged tendon without common post-operative functional complications and adhesions following the tendon repair surgery. However, more comprehensive clinical trials are still needed.
Keywords: Acellular dermal matrix, Zinc oxide nanoparticles, Adhesion, Healing, Flexor tendon, Reconstructive surgery
Copyright and License Information
© 2024 The Author(s).
This work is published by BioImpacts as an open access article distributed under the terms of the Creative Commons Attribution Non-Commercial License (
http://creativecommons.org/licenses/by-nc/4.0/). Non-commercial uses of the work are permitted, provided the original work is properly cited.
Funding Statement
The authors did not receive support from any organization for the submitted work.
Introduction
The function of the human wrist is intimately linked to its flexor and extensor tendons, and their malfunction impacts hand function. The flexor tendons originate from the superficial and deep flexor muscles.1,2 Verdan, in 1960, described the five distinct anatomical zones of flexor tendons, with zone 5 extending from the distal wrist crease to the flexor musculotendinous junction.3 This zone is the most exposed and so the most vulnerable zone for accidental cuts and suicidal and homicidal injuries.4 Injuries to the flexor tendons and surrounding structures are sometimes called spaghetti wrists4,5 and represent a clinical concern since they do not heal without surgery, unlike other tendons.6 The functional importance of zone structures (blood vessels, nerves, and flexor tendons) makes injuries in this area very dangerous, and impeccable management is of primary importance.7,8 All initial flexor tendon repair methods have the same basic principle: execute a surgery with minimal manipulation and sufficient repair power to allow early postoperative movement and rehabilitation, which requires the patient's cooperation and awareness. Rupture, tendon adhesion, and joint contraction are the most prevalent consequences following flexor tendon repair.9,10 Adhesion is a normal aspect of the healing process but can also lead to tendon dysfunction. Therefore, research is in progress to develop medical strategies for preventing tendon adhesion.11
Nanotechnology and tissue engineering are rising as novel fields in plastic and reconstructive surgery (PRS) that often go with regenerative medicine. Acellular dermal matrix (ADM) is a natural scaffold with high histocompatibility. This decellularized graft primarily contains collagen and serves as a great scaffold for host cell implantation and neovascularization.9,12 These properties make human ADMs widely used in wound healing, soft tissue repair, tendon repair, and sports medicine applications. ADM can be especially useful in the augmentation of tendon repair.12-14 ADMs can, in addition to mechanical tendon support, improve the healing process by revascularization, cellular growth, and re-epithelialization in hosts.15-18 The mechanical support the ADM provides reduces the risk of reinjury and adhesion of the tendon in repair procedures. The use of ADMs to augment tendon repair can also provide an additional advantage of reducing the complexity of the surgical procedure by removing the need for a second surgical site to recover autologous donor tissue and thus eliminating the risk of second-site morbidity.19 Furthermore, infection at the donor site can cause many problems for the patient and the surgeon. Hence, an antibacterial ADM can help prevent these problems.
Nanoparticle-based wound care solutions are relatively new compared to traditional materials. Due to their nano-size particles, nanomaterials have appropriate solubility, biocompatibility, and bioavailability in cells and tissues and stimulate repair at the cellular and molecular levels.20,21 Zinc oxide nanoparticles (ZnO-NPs) with higher bioavailability than zinc ions are very desirable for medical and pharmaceutical purposes. ZnO-NPs are recommended for their stability under punitive conditions, low toxicity, and antimicrobial, healing, anticancer, and antioxidant properties.22-26
This study aimed to determine the outcome and devise a protocol in PRS for reducing adhesion and accelerating tendon healing in flexor zone 5 of the hands using an antibacterial ADM.
Materials and Methods
Chemicals
The ZnO-NPs were obtained from US Research Nanomaterials with ≤40 nm particle size. All chemicals and reagents were of analytical grade. Sodium chloride (NaCl), ethylenediaminetetraacetic acid (EDTA), sterile TritonTM X-100 surfactant, 4-(2-hydroxyethyl)-1-piperazineethanesulfonic acid (HEPES) buffer, sodium dodecyl sulfate (SDS), and Karnovsky's fixative (2% paraformaldehyde, 2.5% glutaraldehyde) were purchased from Sigma Aldrich. Fetal bovine serum (FBS), Dulbecco's modified eagle medium (DMEM), phosphate buffer saline (PBS, Tablet), amphotericin B (~80%), penicillin/streptomycin (100X, Tissue Culture Grade), ethanol (≥99.8%), dimethyl sulfoxide (DMSO), thiazolyl blue tetrazolium bromide (98%), Dispase® I, formaldehyde solution, glutaraldehyde solution, trypan Blue, and trypsin were purchased from Sigma-Aldrich (St. Louis, MO, USA).
Preparation and evaluation of acellular dermal matrix
The ADM was produced using skin fragments taken during cosmetic abdominoplasty surgeries with the patient's informed consent. According to the protocol used in our previous studies, after purgation and elimination of subdermal fat tissues and hair, we separated the epidermis in 1 M sodium chloride (NaCl) solution shaken in the incubator at 37 °C for 18 hours. Decellularization was done with 2% SDS solution, 10 mM HEPS buffer, and EDTA solution at 25 °C for 2 hours. Then, the derm was washed thrice in sterile PBS.27 Before lyophilization, ZnO-NPs were coated on the ADM. To evaluate the scaffold, hematoxylin and eosin (H&E), Verhoff, and Alcian blue staining methods were utilized for all samples.
Coating ZnO -NPs on the acellular dermal matrix
Five milligrams of ZnO-NPs were dissolved in 100 mL of deionized water on a magnetic stirrer plate at 250 rpm continuously for 15 minutes at room temperature until they were equally dispersed. Then, 10 mL of ZnO-NPs solution was poured on pieces of ADM (20 mm2) and left in a sonicator bath for 10 minutes at 500 rpm to load the nanoparticles onto the matrix. Finally, the matrices were thoroughly dehumidified and dried in a freeze-dry machine. The dried components of theADM/ZnO-NPs in the plasma machine were sanitized and disinfected before being stored at room temperature until usage.
Investigating the distribution of ZnO -NPs in ADM/ ZnO -NPs scaffold
The micromorphology of ADM/ZnO-NPs was characterized by scanning electron microscopy. The scaffolds were fixed using the Karnowski fixator (2% paraformaldehyde; 2.5% glutaraldehyde), then washed with PBS and deionized water. After that, the samples were dewatered using a graded series of ethanol solutions and dried on a Petri dish. Finally, the samples were detected using a scanning electron microscope after gold plating. Then, we analyzed the distribution of ZnO-NPs in the ADM/ZnO-NPs by scanning electron microscopy with energy-dispersive X-ray spectrometry (SEM-EDS).
Tensile strength assay of the ADM/ ZnO -NPs graft
The tensile characteristics of the ADM/ZnO-NPs graft were determined using a uniaxial tensile test. At a speed of 10 mm/min, tape samples (50×20 mm) were cut and examined. The ASTM D882 standard was used to conduct the tensile test. The load-displacement curve was recorded, as well as the maximum tensile force when the strip broke.11
Cell viability assay
The cell viability on the ADM/ZnO-NPs graft was determined by MTT assay. Human dermal fibroblasts (HDF1BOM; Cell Number: IBRC C10506) cultured in DMEM until the logarithmic growth stage were taken and digested by adding trypsin, then cells (1×104 cell/96-well plate) were seeded on the membranes and incubated for 24, 48, and 72 hours. Subsequently, the MTT reagent was inserted into each well at specified times, and the plates were re-incubated for 4 hours at 37 °C. After removing the culture medium, we added DMSO into each well to dissolve the formazan. Then, the absorbance of the stained formazan yield was measured at 570 nm by an ELISA microplate reader. The MTT assay was carried out in triplicate.
Cell proliferation assay
The fibroblast cells' proliferation on ADM/ZnO-NPs also was assessed by staining the cell nuclei with a fluorescent dye (DAPI). The treatment was carried out on the scaffold/cells in six-well plates for 24 hours. Paraformaldehyde (4%) and Triton X100 were used to fix the cells and then washed with PBS three times. The fixed cells were incubated with DAPI (1 µg/mL) for 10 minutes for staining and washed again with PBS to discard excessive DAPI before observing under fluorescent microscopy (Olympus, Japan) at a peak excitation wavelength of 340 nm.
In vitro antibacterial activity of ADM/ ZnO -NPs
To measure the antimicrobial efficacy, we prepared suspensions of Staphylococcus aureus (ATCC 25923) and Escherichia coli (ATCC 25922) on the surface of Mueller-Hinton agar plates. Then, circles with a diameter of 5 mm from ADM/ZnO-NPs and ADM (control) were cut and placed onto the agar plates. A tetracycline disc was used as the positive control. The diameter of the inhibition zone (DIZ) was measured using a metric ruler after a 24-hour incubation at 37 °C.
Study design
Twenty patients above 18 years old with acute flexor zone 5 injuries without severe bone lesions were chosen. Patients with injuries were not allowed to participate in the research. The research was carried out at Rajaei Medical Center and informed written consent was obtained from all patients. Demographic information, type of injury, and location were obtained through interviews with the patients. Information on the presence of associated lesions and the type of tendon injury was extracted through clinical examination and wound exploration during surgery (Table 1). Whole blood tests and radiographic investigations were done before surgery.
Table 1.
Demography of injury in patients
|
Patients (#)
|
Gender
|
Age (y)
|
Damaged hand
|
Tendon injury
|
Nerve injury
|
|
Control group
|
| 1 |
Male |
39 |
Left |
FPL, FDP (2, 3, 4, and 5) and FDS (2, 3, 4, and 5) |
- |
| 2 |
Male |
42 |
Right |
FPL, PL, FCR, FCU, FDP (5), and FDS (2, 3, and 4) |
- |
| 3 |
Female |
29 |
Left |
FDP (4 and 5) and FDS (2 and 3) |
- |
| 4 |
Male |
48 |
Right |
PL, FCU, FDP (3, 4, and 5), and FDS (3, 4, and 5) |
- |
| 5 |
Male |
21 |
Left |
FDP (2, 3, 4, and 5) and FDS (2, 3, 4, and 5) |
Median |
| 6 |
Male |
30 |
Left |
PL, FCU, and FDS (2, 3, 4, and 5) |
Ulnar |
| 7 |
Male |
26 |
Left |
FCU and FDS (3, 4, and 5) |
- |
| 8 |
Male |
34 |
Right |
FCU |
- |
| 9 |
Male |
21 |
Left |
FDP (2, 3, 4, and 5) |
Ulnar |
| 10 |
Male |
27 |
Left |
FCU and FDS (2, 3, 4, and 5) |
Ulnar |
|
ADM/ZnO-NPs group
|
| 1 |
Male |
45 |
Right |
FDS (2, 3, 4, and 5) |
Median |
| 2 |
Male |
35 |
Left |
FPL, FDP (2, 3, 4, and 5), FDS (2, 3, 4, and 5) |
Median |
| 3 |
Male |
31 |
Left |
FPL, PL, FCR, FCU, FDP (2, 3, 4, and 5), FDS (2, 3, 4, and 5) |
Ulnar |
| 4 |
Male |
20 |
Left |
FDP (3) and FDS (2, 3, 4, and 5) |
Median |
| 5 |
Male |
25 |
Right |
PL, FCU, FDP (3, 4, and 5), and FDS (2, 3, 4, and 5) |
Ulnar |
| 6 |
Male |
28 |
Left |
PL, FCU, and FDS (3, 4, and 5) |
Ulnar |
| 7 |
Male |
38 |
Left |
FCU and FDS (2, 3, 4, and 5) |
- |
| 8 |
Male |
23 |
Right |
FCU and FDS (2, 3, and 4) |
- |
| 9 |
Male |
28 |
Left |
PL, FCU, and FDS (2, 3, and 4) |
Ulnar |
| 10 |
Female |
34 |
Left |
FDS (2, 3, 4, and 5) |
Ulnar |
Abbreviations: FPL, Flexor pollicis longus; PL, Palmaris longus; FCR, Flexor carpi radialis; FDP, Flexor digitorum profundus; FCU= Flexor carpi ulnaris; FDS: Flexor digitorum superficialis.
After resuscitation and pain management, a full limb examination, proximal and distal neurovascular assessment, and skeletal muscle examination were performed as painlessly as feasible. The examination was halted until the patient had been anesthetized. Under general anesthesia, all patients had surgery with a control tourniquet and loupe magnification. Except in cases where both the ulnar and radial arteries were cut and the hand required re-arterialization, the tendons were restored first, followed by the nerves and, ultimately, the arteries. For tendon repair, the core suture repairing technique by four-strand suture with Nylon 3/0 was employed. The tendon repair after the core suture was completed by circumferential epitendinous suturing with Nylon 4/0. In the case of nerve damage, it was repaired with Prolene 8/0.
To lessen the complications caused by tendon adhesion, in the treatment group (10 patients), the ADM/ZnO-NPs in desirable size were inserted in the repair site and fixed with Monocryl 4/0. The control group (10 patients) did not receive the ADM/ZnO-NPs. Postoperative physiotherapy was started for all patients after 24 hours. Following the removal of the splint during physiotherapy, the patient's activity was monitored for 2 weeks with active extension controlled passive flexion and passive range of motion exercises, followed by four weeks of holding objects without exerting pressure. After six weeks, holding and lifting light-weight objects were allowed with progressively increasing resistance to flexion. After 6 weeks, the splint was worn only at night for another 2 weeks.
Postoperative clinical evaluations
The functional outcome of flexor tendon repair was assessed by Buck-Gramcko II criteria based on the nail-to-palm crease distance, total extension defect, and modified total active motion score after eight weeks. Based on the score received, the results were evaluated using a four-stage classification system.28
Statistical analysis
All data are expressed as mean ± standard deviation (SD). GraphPad Prism (version 9.3.1, GraphPad Software, Inc., La Jolla, CA, USA) statistical software was used for all statistical analyses. Comparisons between the groups were performed using the unpaired t-test, two-way analysis of variance (ANOVA), and Fisher’s exact test, as appropriate. P < 0.05 was considered to reflect statistical significance.
Results
Histological evaluation of the ADM scaffold and SEM analysis of ADM and ADM/ ZnO -NPs graft
After H&E staining of ADM, no cells were detected, and the collagen fibers were stained in red. ADM staining Using Verhoff and Alcianblue staining methods directed the presence of elastin fibers in black color and glycosaminoglycans in blue color revealed in the ADM scaffold (Fig. 1). Cross-sectional SEM analysis revealed that after the acellularization process, no cells existed in the ADM/ZnO-NPs scaffold, with only the normal appearance of the dermal collagen structure and nanoparticles being visible in the SEM micrograph.

Fig. 1.
(A) H&E staining and (B) cross-sectional micrograph of the acellular dermal matrix (ADM) graft.
.
(A) H&E staining and (B) cross-sectional micrograph of the acellular dermal matrix (ADM) graft.
Fig. 2 shows the SEM image and the EDS spectrum of ADM/ZnO-NPs. Yellow, gray, and purple dots represent the distribution of C, O, and Zn within the ADM. As it is obvious, elements, especially O and Zn, are distributed homogeneously.

Fig. 2.
(A) Scanning electron microscope (SEM) image, (B-D) elemental mapping analysis, and (C) energy-dispersive X-ray spectrometry (EDS) analysis of the acellular dermal matrix and zinc oxide nanoparticles (ADM-ZnO-NPs) scaffold.
.
(A) Scanning electron microscope (SEM) image, (B-D) elemental mapping analysis, and (C) energy-dispersive X-ray spectrometry (EDS) analysis of the acellular dermal matrix and zinc oxide nanoparticles (ADM-ZnO-NPs) scaffold.
Mechanical evaluation of the ADM/ ZnO -NPs graft
The results of mechanical evaluations can be seen in Fig. 3. Load-displacement curves of ADM and ADM/ZnO-NPs graft are illustrated in Fig. 3A. The maximum tensile force in the ADM/ZnO-NPs scaffold (172.2 ± 10.87 MPa) was significantly (P<0.05) higher than in the ADM scaffold (152.7 ± 10.89 MPa) (Fig. 3B).

Fig. 3.
(A) Load–displacement curves and (B) maximum tensile force of the acellular dermal matrix (ADM) and ADM-zinc oxide nanoparticles (ZnO-NPs) grafts. *P<0.05.
.
(A) Load–displacement curves and (B) maximum tensile force of the acellular dermal matrix (ADM) and ADM-zinc oxide nanoparticles (ZnO-NPs) grafts. *P<0.05.
Cell viability of human dermal fibroblasts in the ADM/ ZnO -NPs scaffold
The results of the cell viability assay are represented in Fig. 4A. At 24 and 48 hours, the percentage of cell viability in the ADM (105.73 ± 12.02 and 145.28 ± 7.70, respectively) and ADM/ZnO-NPs (120.44 ± 9.75 and 166.05 ± 9.90, respectively) scaffold had no significant difference. At 72 hours, the cell viability was remarkably (P<0.05) higher in the ADM/ZnO-NPs scaffold (176.07 ± 5.21) in comparison with the ADM graft (155.75 ± 3.63).

Fig. 4.
(A) Percentage of cell viability at 24, 48, and 72 hours. Parts (B) and (C) show cross-sectional micrographs of the acellular dermal matrix (ADM) and ADM-zinc oxide nanoparticles (ZnO-NPs) scaffolds, respectively, cultured with human dermal fibroblasts (HDFs). Parts (D) and (E) show DAPI staining of ADM and ADM-ZnO-NPs scaffolds, respectively, cultured with HDFs. **P<0.01.
.
(A) Percentage of cell viability at 24, 48, and 72 hours. Parts (B) and (C) show cross-sectional micrographs of the acellular dermal matrix (ADM) and ADM-zinc oxide nanoparticles (ZnO-NPs) scaffolds, respectively, cultured with human dermal fibroblasts (HDFs). Parts (D) and (E) show DAPI staining of ADM and ADM-ZnO-NPs scaffolds, respectively, cultured with HDFs. **P<0.01.
Disk diffusion antibacterial assay for the ADM/ ZnO -NPs graft
The disc diffusion assay demonstrated that the ADM/ZnO-NPs graft was effective against S. aureus and E. coli (Fig. 5A and B, respectively). The DIZ of ADM/ZnO-NPs samples was 3.85 ± 0.72 mm for S. aureus and 6.24 ± 1.08 mm for E. coli (Fig. 5C and D, respectively). Both control and ADM samples did not have an inhibition zone.
Fig. 5.
Antibacterial test with disk diffusion method. Parts (A) and (B) show agar plates cultured with Staphylococcus aureus and Escherichia coli, respectively. Parts (C) and (D) show the diameter of the inhibition zone (DIZ) of the acellular dermal matrix and zinc oxide nanoparticles (ADM-ZnO-NPs) compared to antibiotic discs for S. aureus and E. coli, respectively.
.
Antibacterial test with disk diffusion method. Parts (A) and (B) show agar plates cultured with Staphylococcus aureus and Escherichia coli, respectively. Parts (C) and (D) show the diameter of the inhibition zone (DIZ) of the acellular dermal matrix and zinc oxide nanoparticles (ADM-ZnO-NPs) compared to antibiotic discs for S. aureus and E. coli, respectively.
Patients’ demographics
The mean age was 31.70 ± 8.97 and 30.70 ± 30.70 years in the control and ADM/ZnO-NPs groups, respectively, and no significant difference was found between the groups. In each group, nine (90%) patients were males, and 1 (10%) patient was female (Table 2).
Table 2.
Demographic characteristics of the patients
|
|
Group
|
P
value
|
|
Control (n=10)
|
ADM/ZnO-NPs (n=10)
|
| Age |
31.70 ± 8.97 |
30.70 ± 30.70 |
0.790 |
| Gender |
|
|
|
| Male (n) |
9 |
9 |
> 0.999 |
| Female (n) |
1 |
1 |
Abbreviations: n=number of patients; ADM=acellular dermal matrix; ZnO-NPs=zinc oxide nanoparticles.
Data of age are expressed as mean ± SD.
Statistical analysis of age and gender was carried out using unpaired t-test and Fisher exact test, respectively.
Postoperative evaluation
Functional outcomes according to the Buck-Gramcko II criteria are shown in Fig. 6. After four weeks, 20% of patients in the control group had a poor outcome, 70% of them had a fair outcome, and 10% had a good outcome. At the same time, patients in the ADM/ZnO-NPs group had 40% fair and 60% good outcomes. After six weeks, functional outcomes in the control group were 40% poor, 50% fair, and 10% excellent; in the ADM/ZnO-NPs group, they were 70% good and 30% excellent. After 8 weeks, 60% of patients in the control group had a good outcome, and the other 40% had an excellent outcome. At all-time intervals, patients in the ADM/ZnO-NPs group had significantly higher outcome points than those in the control group.

Fig. 6.
(A-C) The recovery classification and (D-E) recorded points from the function of flexor tendons in zone 5 using Buck-Gramcko II criteria at 4, 6, and 8 weeks after surgery, respectively. **P<0.01 and ***P<0.001.
.
(A-C) The recovery classification and (D-E) recorded points from the function of flexor tendons in zone 5 using Buck-Gramcko II criteria at 4, 6, and 8 weeks after surgery, respectively. **P<0.01 and ***P<0.001.
Fig. 7 shows the postoperative clinical evaluation of the flexion of fingers in two cases after 28 days (A-D and E-H, respectively). As it is obvious, both patients could successfully flex their fingers.

Fig. 7.
Postoperative photographs show successful flexion of fingers in two cases (A-D and E-H, respectively).
.
Postoperative photographs show successful flexion of fingers in two cases (A-D and E-H, respectively).
Discussion
Lacerations to the volar wrist surface have the potential to be severely debilitating, mainly due to the superficial location and high density of tendons, nerves, and arteries in that area.29 Adhesion formation post-tendon repair represents a major challenge. Different options for preventing adhesions after flexor tendon repair have been introduced: modifying the suture technique, optimizing postoperative resting, regulating tissue remodeling and inflammation, and placing mechanical barriers between the tendons and tissues for maintaining a gliding surface.30,31 ADM/ZnO-NPs act as a barrier between the tendons and proliferating tissues, promoting healing and preventing adhesion.32-34 This graft is ideal for tissue healing because it not only provides a proper environment for fibroblast cells to multiply and migrate but also does not trigger the patient's immune system due to its cell-free nature.12,35 With the existence of collagen types I and III, elastin fibers, glycosaminoglycans (GAGs), glycoproteins (GPs), proteoglycans (PGs), fibronectin, fibrin, heparin, and integrin, this product is ideal for connecting, proliferating, and migrating skin cells.36-38 Hence, we investigated the physical and chemical characteristics of ADM/ZnO-NPs, including tensile strength, morphology, viability, and antibacterial characteristics. Our findings revealed that the ZnO-NPs did not affect the biomechanical or biological characteristics of ADM. According to histological examinations, elastin fibers and the secretory matrix of glycosaminoglycans were found in the scaffold, indicating that the dermis in ADM/ZnO-NPs had a complete and adequate structure. Scanning electron microscopy validated the dense and integrated structure of ADM/ZnO-NPs. ZnO-NPs on ADM can produce considerable antibacterial capabilities against both Gram-positive and Gram-negative bacteria. As a result of its antibacterial activity, no infection can be noticed in the surgical area of the flexor tendon using this scaffold.
In line with our findings, previous studies have reported that loading metal-NPs on the ADM reinforced their physiochemical properties and added antibacterial activity to them.39 Chen et al have indicated that porcine ADM graft containing silver-NPs not only had better structural and thermal stability but also exhibited remarkable antibacterial properties and enhanced wound healing.40 Similarly Tao et al have revealed that ADMs immersed in different concentrations of the silver-NPs possess antibacterial activity as well as an accelerated healing process while decreasing intraperitoneal adhesion and surgical site infection in a rat model of abdominal wall defect.41
In this study, all 20 patients successfully underwent zone 5 augmented flexor tendon repair surgery. No patient showed any signs of infection or had an adverse reaction to the ADM/ZnO-NPs. Therefore, the ADM/ZnO-NPs scaffold has various factors that facilitate recovery and return of hand function after tendon repair.32 Despite the shortage of similar clinical studies on zone 5 flexor tendon injuries, our study indicates the benefits of using the specified allograft in such cases. The complete absence of both infections and postoperative complications is also notable, though these findings should be interpreted with caution considering the small sample size. To the best knowledge of the authors, this study is the first clinical trial that developed a modified ADM with antibacterial properties and applied it for repairing tendon damage.
Cole et al used an ADM to restore the Achilles tendon, showing that the surgery was fully successful without incidences of rupture or difficulties that needed extra therapy.42 Branch and colleagues studied tendon transplanting with an ADM to repair the Achilles tendon and other leg and ankle tendons and found that lower volumes of ADM produce more strength in the tendon.43 In another study, animals with rotator cuff tendon abnormalities were given a topical treatment of fibroblast growth factor along with ADM; the results proved that ADM was effective.44
Based on the Buck-Gramcko II criteria, the functional outcomes of the flexor tendon in zone 5 following surgery were better in the ADM/ZnO-NPs group compared with the control group. This could be because the use of ADM/ZnO-NPs in flexor tendon zone 5 restoration resulted in no infection and adhesion in the injured area after healing.
Although the allograft might not have augmented healing, the absence of infection supports the safe use of allografts in flexor tendon repair procedures.
However, the lack of similar studies made comparisons difficult, which also denotes the importance of small pilot studies. Future investigators could use the present results in developing more rigorous randomized controlled trials or prospective cohort studies.
The limitation of the present clinical trial was the small patient population and unblinded outcomes assessors.
Conclusion
The present study confirmed that ADM/ZnO-NPs, as an anti-adhesion barrier, can improve functional consequences after surgery in patients with an injured zone 5 flexor tendon. Our findings indicate that ADM/ZnO-NPs can help repair the damaged area without complications and adhesion in tendon repair surgery, though more comprehensive clinical trials are needed.
Research Highlights
What is the current knowledge?
√ Flexor tendon injury is one of the most common hand injuries, especially in athletes, construction workers, and military personnel.
√ There are various postoperative complications after traditional tendon repair medical strategies, including tendon scar tissue formation, adhesion, insufficient mechanical strength for early active mobilization, and infections.
√ ADM has been applied for tendon augmentation in Achilles tendon repair and as a tendon scaffold in tendon gap repair.
What is new here?
√ ADM coated with ZnO-NPs increased the percent of cell viability.
√ ADM coated with ZnO-NPs had intermediate antibacterial properties.
√ ADM coated with ZnO-NPs improved hand function after surgery in patients with flexor tendon injury at zone 5.
Acknowledgments
The authors wish to thank the respected colleagues and staff of Shahid Rajaee Hospital at Shiraz University of Medical Sciences for their invaluable assistance.
Ethical Statement
This study was approved by the Ethics Committee of Shiraz University of Medical Sciences, Shiraz, Iran (Ethical code: IR.SUMS.MED.REC.1400.377; Approval code: 15203). All experiments were directed according to the ethical standards of the 1964 Helsinki Declaration..
Competing Interests
The authors declare no conflicts of interest.
References
- Boyer MI, Strickland JW, Engles D, Sachar K, Leversedge FJ. Flexor tendon repair and rehabilitation: state of the art in 2002. Instr Course Lect 2003; 52:137-61. doi: 10.2106/00004623-200209000-00025 [Crossref] [ Google Scholar]
- Tang JB. New Developments Are Improving Flexor Tendon Repair. PlastReconstr Surg 2018; 141:1427-37. doi: 10.1097/PRS.0000000000004416 [Crossref] [ Google Scholar]
- Venkatramani H, Varadharajan V, Bhardwaj P, Vallurupalli A, Sabapathy SR. Flexor tendon injuries. J Clin Orthop Trauma 2019; 10:853-61. doi: 10.1016/j.jcot.2019.08.005 [Crossref] [ Google Scholar]
- Atilgan N, Duman N, Colak TS, Korucu IH, Demiryurek M. Multidisciplinary treatment and functional outcome evaluation of combined injuries of nerves, vessels, and flexor tendons: spaghetti wrist. Eur Rev Med Pharmacol Sci 2022; 26:8808-15. doi: 10.26355/eurrev_202212_30552 [Crossref] [ Google Scholar]
- Boynuyogun E, Ozdemir DM, Firat T, Uzun H, Aksu AE. Combined nerve, vessel, and tendon injuries of the volar wrist: Multidisciplinary treatment and functional outcomes. Hand Surg Rehabil 2021; 40:729-36. doi: 10.1016/j.hansur.2021.07.009 [Crossref] [ Google Scholar]
- Mehdi Nasab SA, Sarrafan N, Saeidian SR, Emami H. Functional outcome of flexor tendon repair of the hand at Zone 5 and post operative early mobilization of the fingers. Pak J Med Sci 2013; 29:43-6. doi: 10.12669/pjms.291.2563 [Crossref] [ Google Scholar]
- Kabak S, Halici M, Baktir A, Turk CY, Avsarogullari L. Results of treatment of the extensive volar wrist lacerations: 'the spaghetti wrist'. Eur J Emerg Med 2002; 9:71-6. doi: 10.1097/00063110-200203000-00017 [Crossref] [ Google Scholar]
- Yuksel F, Peker F, Acikel C, CelIkoz B. Secondhand management of "spaghetti wrist": do not hesitate to explore. Ann Plast Surg 2002; 49:500-4. doi: 10.1097/00000637-200211000-00010 [Crossref] [ Google Scholar]
- Gowda AU, Chang SM, Chopra K, Matthews JA, Sabino J, Stromberg JA. Porcine acellular dermal matrix (PADM) vascularises after exposure in open necrotic wounds seen after complex hernia repair. International Wound Journal 2016; 13:972-6. doi: 10.1111/iwj.12558 [Crossref] [ Google Scholar]
- Liu S, Kang Q, Zhang R, Li Y, Bao R. Tendon Adhesion and Novel Solutions. Tendons-Trauma, Inflammation, Degeneration, and Treatment: IntechOpen; 2022. 10.5772/intechopen.108019.
- Sobhanian P, Khorram M, Hashemi SS, Mohammadi A. Development of nanofibrous collagen-grafted poly (vinyl alcohol)/gelatin/alginate scaffolds as potential skin substitute. Int J Biol Macromol 2019; 130:977-87. doi: 10.1016/j.ijbiomac.2019.03.045 [Crossref] [ Google Scholar]
- Nazempour M, Mehrabani D, Mehdinavaz-Aghdam R, Hashemi SS, Derakhshanfar A, Zare S. The effect of allogenic human Wharton's jelly stem cells seeded onto acellular dermal matrix in healing of rat burn wounds. J Cosmet Dermatol 2020; 19:995-1001. doi: 10.1111/jocd.13109 [Crossref] [ Google Scholar]
- Lee YJ, Kanchwala SK, Cho H, Jolly JC, Jablonka E, Tanis M. Natural Shaping of Acellular Dermal Matrices for Implant-Based Breast Reconstruction via Expansile Kirigami. Adv Mater 2023; 35:e2208088. doi: 10.1002/adma.202208088 [Crossref] [ Google Scholar]
- Lee S, Koh KH, Shin SJ. Superior Capsule Reconstruction Using an Acellular Dermal Matrix Allograft Combined With Remnant Tendon Augmentation for Irreparable Rotator Cuff Tear. Arthrosc Tech 2023; 12:e241-e6. doi: 10.1016/j.eats.2022.10.013 [Crossref] [ Google Scholar]
- Aurora A, McCarron J, Iannotti JP, Derwin K. Commercially available extracellular matrix materials for rotator cuff repairs: state of the art and future trends. J Shoulder Elbow Surg 2007; 16:S171-8. doi: 10.1016/j.jse.2007.03.008 [Crossref] [ Google Scholar]
- Fernandez-Moure JS, Van Eps JL, Rhudy JR, Cabrera FJ, Acharya GS, Tasciotti E. Porcine acellular lung matrix for wound healing and abdominal wall reconstruction: A pilot study. J Tissue Eng 2016; 7:2041731415626018. doi: 10.1177/2041731415626018 [Crossref] [ Google Scholar]
- Wainwright DJ. Use of an acellular allograft dermal matrix (AlloDerm) in the management of full-thickness burns. Burns 1995; 21:243-8. doi: 10.1016/0305-4179(95)93866-i [Crossref] [ Google Scholar]
- Livesey SA, Herndon DN, Hollyoak MA, Atkinson YH, Nag A. Transplanted acellular allograft dermal matrixPotential as a template for the reconstruction of viable dermis. Transplantation 1995; 60:1-9. doi: 10.1097/00007890-199507150-00001 [Crossref] [ Google Scholar]
- Lee DK. A preliminary study on the effects of acellular tissue graft augmentation in acute Achilles tendon ruptures. J Foot Ankle Surg 2008; 47:8-12. doi: 10.1053/j.jfas.2007.08.015 [Crossref] [ Google Scholar]
- Sanati P, Chua LS, Nasiri R, Hashemi SS. Nanoencapsulation of Andrographolide Rich Extract for the Inhibition of Cervical and Neuroblastoma Cancer Cells. J Biomed Nanotechnol 2020; 16:1370-80. doi: 10.1166/jbn.2020.2973 [Crossref] [ Google Scholar]
- Solidum JGN, Ceriales JA, Ong EP, Ornos EDB, Relador RJL, Quebral EPB. Nanomedicine and nanoparticle-based delivery systems in plastic and reconstructive surgery. MaxillofacPlastReconstr Surg 2023; 45:15. doi: 10.1186/s40902-023-00383-9 [Crossref] [ Google Scholar]
- Batool M, Khurshid S, Qureshi Z, Daoush WM. Adsorption, antimicrobial and wound healing activities of biosynthesised zinc oxide nanoparticles. Chemical Papers 2020; 75:893-907. doi: 10.1007/s11696-020-01343-7 [Crossref] [ Google Scholar]
- Khalid A, Khan R, Ul-Islam M, Khan T, Wahid F. Bacterial cellulose-zinc oxide nanocomposites as a novel dressing system for burn wounds. CarbohydrPolym 2017; 164:214-21. doi: 10.1016/j.carbpol.2017.01.061 [Crossref] [ Google Scholar]
- Mishra PK, Mishra H, Ekielski A, Talegaonkar S, Vaidya B. Zinc oxide nanoparticles: a promising nanomaterial for biomedical applications. Drug Discov Today 2017; 22:1825-34. doi: 10.1016/j.drudis.2017.08.006 [Crossref] [ Google Scholar]
- Akbar A, Sadiq MB, Ali I, Muhammad N, Rehman Z, Khan MN. Synthesis and antimicrobial activity of zinc oxide nanoparticles against foodborne pathogens Salmonella typhimurium and Staphylococcus aureus. Biocatalysis and Agricultural Biotechnology 2019; 17:36-42. doi: 10.1016/j.bcab.2018.11.005 [Crossref] [ Google Scholar]
- Kamal A, Saba M, Ullah K, Almutairi SM, AlMunqedhi BM, Ragab abdelGawwad M. Mycosynthesis, Characterization of Zinc Oxide Nanoparticles, and Its Assessment in Various Biological Activities. Crystals 2023; 13:171. doi: 10.3390/cryst13020171 [Crossref] [ Google Scholar]
- Mehrabani D, Nazempour M, Mehdinavaz-Aghdam R, Hashemi SS, Jalli R, Moghadam MS. MRI tracking of human Wharton's jelly stem cells seeded onto acellular dermal matrix labeled with superparamagnetic iron oxide nanoparticles in burn wounds. Burns Trauma 2022; 10:tkac018. doi: 10.1093/burnst/tkac018 [Crossref] [ Google Scholar]
- Chan T, Ho C, Lee W, Fung Y, Law Y, Tsang C. Functional outcome of the hand following flexor tendon repair at the ‘no man's land’. Journal of Orthopaedic Surgery 2006; 14:178-83. doi: 10.1177/230949900601400214 [Crossref] [ Google Scholar]
- Puckett CL, Meyer VH. Results of treatment of extensive volar wrist lacerations: the spaghetti wrist. PlastReconstr Surg 1985; 75:714-21. doi: 10.1097/00006534-198505000-00018 [Crossref] [ Google Scholar]
- Bukhari AJ, Saleem M, Bhutta AR, Khan AZ, Abid KJ. Spaghetti wrist: management and outcome. J Coll Physicians Surg Pak 2004; 14:608-11. doi: 10.2004/JCPSP.608611 [Crossref] [ Google Scholar]
- Khanna A, Friel M, Gougoulias N, Longo UG, Maffulli N. Prevention of adhesions in surgery of the flexor tendons of the hand: what is the evidence?. Br Med Bull 2009; 90:85-109. doi: 10.1093/bmb/ldp013 [Crossref] [ Google Scholar]
- Lee YJ, Ryoo HJ, Shim HS. Prevention of postoperative adhesions after flexor tendon repair with acellular dermal matrix in Zones III, IV, and V of the hand: A randomized controlled (CONSORT-compliant) trial. Medicine (Baltimore) 2022; 101:e28630. doi: 10.1097/MD.0000000000028630 [Crossref] [ Google Scholar]
- Yoon D, Cho YS, Joo SY, Seo CH, Cho YS. A clinical trial with a novel collagen dermal substitute for wound healing in burn patients. Biomater Sci 2020; 8:823-9. doi: 10.1039/c9bm01209e [Crossref] [ Google Scholar]
- Hashemi SS, Mohammadi AA, Kabiri H, Hashempoor MR, Mahmoodi M, Amini M. The healing effect of Wharton's jelly stem cells seeded on biological scaffold in chronic skin ulcers: A randomized clinical trial. J Cosmet Dermatol 2019; 18:1961-7. doi: 10.1111/jocd.12931 [Crossref] [ Google Scholar]
- Hashemi SS, Mohammadi AA, Moshirabadi K, Zardosht M. Effect of dermal fibroblasts and mesenchymal stem cells seeded on an amniotic membrane scaffold in skin regeneration: A case series. J Cosmet Dermatol 2021; 20:4040-7. doi: 10.1111/jocd.14043 [Crossref] [ Google Scholar]
- Huang SP, Hsu CC, Chang SC, Wang CH, Deng SC, Dai NT. Adipose-derived stem cells seeded on acellular dermal matrix grafts enhance wound healing in a murine model of a full-thickness defect. Ann Plast Surg 2012; 69:656-62. doi: 10.1097/SAP.0b013e318273f909 [Crossref] [ Google Scholar]
- Nie C, Yang D, Morris SF. Local delivery of adipose-derived stem cells via acellular dermal matrix as a scaffold: a new promising strategy to accelerate wound healing. Med Hypotheses 2009; 72:679-82. doi: 10.1016/j.mehy.2008.10.033 [Crossref] [ Google Scholar]
- Wang Q, Jin Y, Deng X, Liu H, Pang H, Shi P. Second-harmonic generation microscopy for assessment of mesenchymal stem cell-seeded acellular dermal matrix in wound-healing. Biomaterials 2015; 53:659-68. doi: 10.1016/j.biomaterials.2015.03.011 [Crossref] [ Google Scholar]
- Chen Y, Liu X, Zheng X, Huang X, Dan W, Li Z. Advances on the modification and biomedical applications of acellular dermal matrices. Journal of Leather Science and Engineering 2022; 4:19. doi: 10.1186/s42825-022-00093-4 [Crossref] [ Google Scholar]
- Chen Y, Dan N, Dan W, Liu X, Cong L. A novel antibacterial acellular porcine dermal matrix cross-linked with oxidized chitosan oligosaccharide and modified by in situ synthesis of silver nanoparticles for wound healing applications. Mater Sci Eng C Mater Biol Appl 2019; 94:1020-36. doi: 10.1016/j.msec.2018.10.036 [Crossref] [ Google Scholar]
- Tao Y, Cheng XB, Wang ZJ, Tan RW, Yu XQ, Zhai ZW. The application possibility of acellular dermal matrix decorated with nano-silver in the reconstruction of contaminated abdominal wall. Mater Sci Eng C Mater Biol Appl 2021; 119:111645. doi: 10.1016/j.msec.2020.111645 [Crossref] [ Google Scholar]
- Cole W, Samsell B, Moore MA. Achilles Tendon Augmented Repair Using Human Acellular Dermal Matrix: A Case Series. J Foot Ankle Surg 2018; 57:1225-9. doi: 10.1053/j.jfas.2018.03.006 [Crossref] [ Google Scholar]
- Branch JP. A tendon graft weave using an acellular dermal matrix for repair of the Achilles tendon and other foot and ankle tendons. J Foot Ankle Surg 2011; 50:257-65. doi: 10.1053/j.jfas.2010.12.015 [Crossref] [ Google Scholar]
- Ide J, Kikukawa K, Hirose J, Iyama K, Sakamoto H, Mizuta H. The effects of fibroblast growth factor-2 on rotator cuff reconstruction with acellular dermal matrix grafts. Arthroscopy 2009; 25:608-16. doi: 10.1016/j.arthro.2008.11.011 [Crossref] [ Google Scholar]